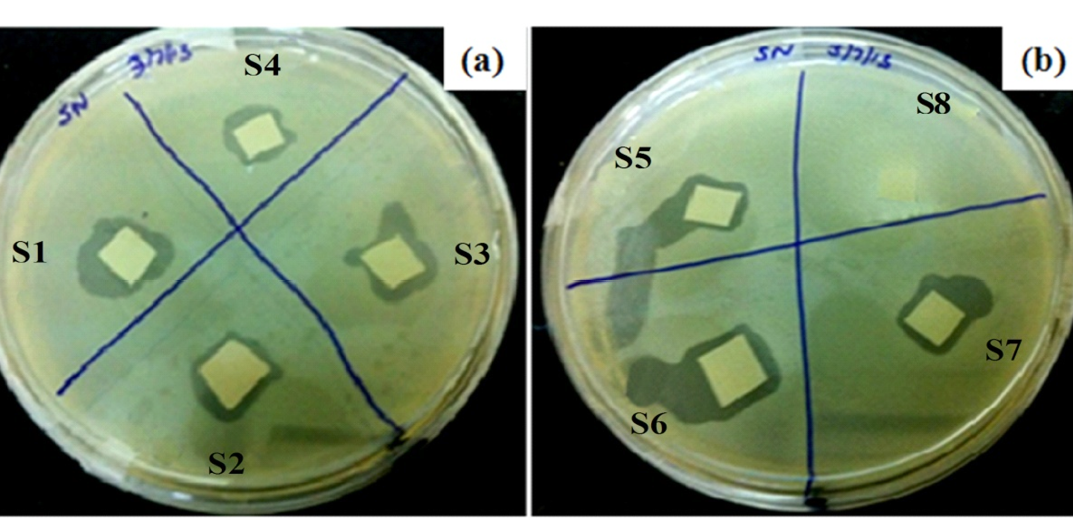

Advances in Animal and Veterinary Sciences
Schematic of effect of binding interactions (electrostatic, covalent and physiosorption) on phage orientation while immobilization on Silica NPs LB film substrate
Susceptibility of bacteria Staphylococcus arlettae SDKU and SDKU6 against various antibiotics
Isolation of phages against SDKU6 by (a) Tubidity disappearance and (b) Agar overlay Method
Characterisation of phages by TEM imaging
Host specificty test of phages against (a) Gram positive and (b) Gram negative bacterial strains
(a) SEM image (b) Isotherm of synthesized silica NPs
Effect of immobilization approaches on bactericidal efficiency using plaque assay